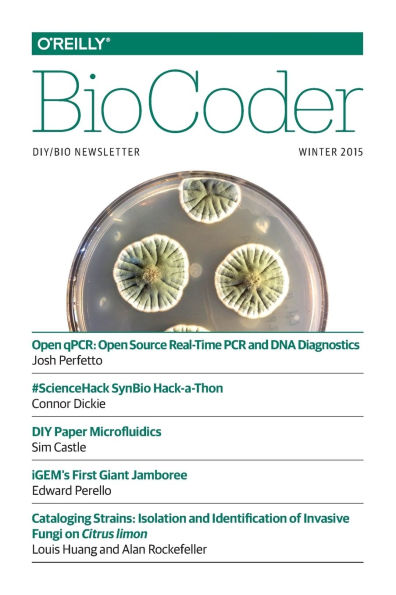
Biocoder #6: Winter 2015

1
/
of
1
O'Reilly Media
Biocoder #6: Winter 2015
Biocoder #6: Winter 2015
ISBN-13: 9781491918678
Regular price
$10.51
Regular price
Sale price
$10.51
Unit price
/
per
Couldn't load pickup availability
BioCoder is a quarterly newsletter for DIYbio, synthetic bio, and anything related. You'll discover: Articles about interesting projects and experiments, such as the glowing plant Articles about tools, both those you buy and those you build Visits to DIYbio laboratories Profiles of key people in the community Announcements of events and other items of interest Safety pointers and tips about good laboratory practice Anything that's interesting or useful: you tell us! And BioCoder is free (for the time being), unless you want a dead-tree version. We'd like BioCoder to become self supporting (maybe even profitable), but we'll worry about that after we've got a few issues under our belt. If you'd like to contribute, send email to BioCoder@oreilly.com. Tell us what you'd like to do, and we'll get you started.
- • Author: O'Reilly Media
- • Publisher: O'Reilly Media
- • Publication Date: Mar 03, 2015
- • Number of Pages: 78 pages
- • Language: English
- • Binding: Paperback
- • ISBN-10: 1491918675
- • ISBN-13: 9781491918678
Share